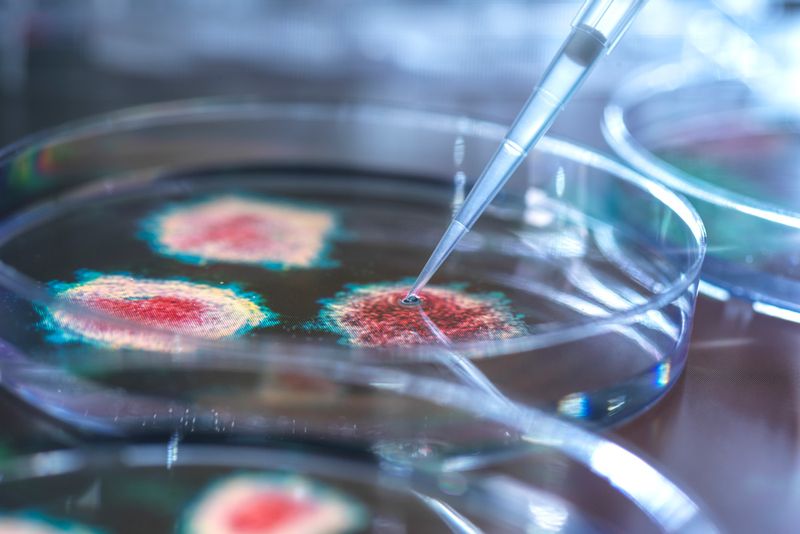

1日あたりの死者数は7月29日だけで1461人を記録。1日あたりの増加数としては、5月27日の1484人に次ぐ数値となった。24時間にわたり、1分間に1人の米国人が、新型コロナウイルス感染症によって死亡したことになる。総症例数は440万件に達した。
研究によると、新型コロナウイルス感染症によって死亡した男性の数は女性の約2倍にのぼる。加えて今回のパンデミックでは、米国の黒人に特に大きな被害が及んでいる。COVID追跡プロジェクト(The COVID Tracking Project)によれば、黒人の死亡率は白人の2倍以上にのぼる。新型コロナウイルスはこれまでに3万648人の黒人の命を奪っており、人種が判明している米国での総死者数の23%を占める。
COVID追跡プロジェクトは人種・民族別の総死者数を発表しており、7月30日の時点で、人口10万人あたり74人の黒人が死亡した。対して、白人では10万人あたり30人、アジア系米国人では10万人あたり31人にとどまっている。ネイティブアメリカンおよびアラスカ先住民、ヒスパニックおよびラテン系米国人の10万人あたりの死者数も、ともに40人とやや多い。
新型コロナウイルスが経済的・人種的格差を露呈させる例として、シカゴの状況は典型的だ。黒人住民は、同市の人口構成の30%でしかないにもかかわらず、5月下旬の時点で、同市の新型コロナウイルスによる死者の60%が黒人だった。
米国の人口10万人あたりの新型コロナウイルス感染症による死者数(人種・民族別)